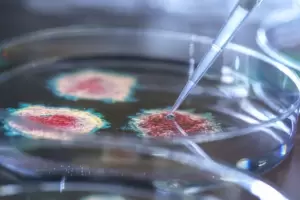
micron: un informe del Reino Unido muestra qu vacuna usada como refuerzo genera mayor proteccin

Sociedad
Contagios en retroceso en la Argentina: los casos cayeron más de un 25% en la última semana
Se reportaron 7902 nuevos contagios y 61 muertes. Con estas cifras, el total de afectados desde el inicio de la pandemia ascendió a 9.697.763 y los fallecidos a 129.830. Cuáles son los últimos datos que difundió el Ministerio de Salud sobre la pandemia.
11/09/2022 18.24